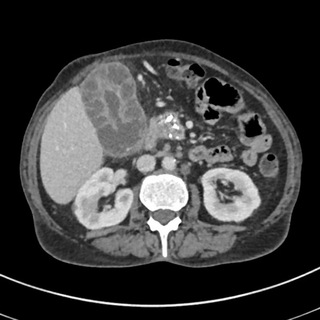
Логотип @shortradiology - Radiology short cases

Telegram каналы: Здоровье
Все
Другое
Чаты
Новости и СМИ
Блоги
Технологии
Образование
Музыка
Игры
Развлечения
Красота
Для взрослых
Фото
Финансы
Магазины и продажи
Политика
Психология
Спорт и фитнес
Здоровье
Региональные
Путешествия
Фильмы и сериалы
Криптовалюты
Цитаты
Религия
Экономика
Дизайн
Еда
Книги
Искусство
Прогнозы и ставки
Карьера
Маркетинг
Авто и мото
Гороскопы и эзотерика
Природа и животные
Для родителей
Языки
Строительство и ремонт
Юриспруденция
Инстаграм
Недвижимость
Рукоделие
Скидки и акции
Аниме
Даркнет
Видео
Бизнес
Война и конфликты
Подкасты
Медицина

Похудение. Диета. Фитнес. Йога
@fitnes_figura
12.8K
№ 5001005843
Если ты боялась начать вести здоровую жизнь, то сейчас самое время. Хватит искать причины - просто начни и радуйся!
Вопросы рекламы: @Ae_sered

Umka Family
@UmkaFamily
12.7K
🔹Канал о честной медицине, основанной только на доказательствах
🔹Новости клиники Умка Фэмили

Infermieritalia
@infermieritalia
12.7K
Il canale nasce per tenere aggiornati tutti gli infermieri su ciò che concerne il nostro mondo lavorativo (procedure, concorsi e avvisi pubblici, offerte di lavoro, FAD ed ECM totalmente gratuiti)

Советы по Йоге от Тренера
@trener_yogi
12.7K
Лучшие советы и фишки по Йоге
Зарегистрирован в РКН: LINK
По вопросам рекламы - @katyaboll

POUVOIRS SPIRITUELS ET MÉDECINALES DES PLANTES EN AFRIQUE ☘☘☘🌿
@psmpa99543880
12.7K
Bienvenue sur le canal Télégram de "Pouvoirs spirituels et médicinales des plantes en Afrique" 🌿
Explorez les secrets spirituels et médicinaux des plantes africaines. 🌱✨

PhNote Collection
@clinical_notes1
12.7K
_معلومات صيدلانية وطبية
_تدريب للصيدلاني
_أدويه وميكانزم ومراجع علمية
الصيدلة والطب بين يديك
_للتواصل خاص مع الادمـن @aaa9b

Похудение с помощью Йоги
@hudey_yogoy
12.7K
Фитнес тренировки с нами
Зарегистрирован в РКН: LINK
По вопросам рекламы строго к - @alexandralion

Профессия – хирург
@profsurgeon
12.7K
Пишем для хирургов. Новости доказательной медицины, зарубежные исследования, обзоры монографий, клинические случаи.
ИД Медмедиа idmedmedia.ru
Связь с редакцией и по вопросам сотрудничества @id_medmedia
Регистрация в РКН LINK

Архив Матриц Гаряева. №2
@matrix_original_2
12.7K
Здесь собраны все матриц Гаряева

Bolgan - Studi e Salute
@bolganstudiesalute
12.7K
Canale collegato al sito www.studiesalute.org
info@studiesalute.org
NON rispondete a profili falsi di invito a visite o altro a pagamento!! Rispondo solo a richieste d'informazioni tramite la mail del sito o LINK

Будь здоров, МУЖИК!
@mens_healf
12.7K
Самый известный сексолог в Telegram
Откровенно и без цензуры о твоём здоровье
Очнись, забивать болт на собственное здоровье уже не🔝

Sia_g
@sia_g_telegram
12.7K

Красивая Фигура | Управление Весом
@beautiful_figure
12.6K
№ 5000542162
Красивая фигура в первую очередь нужна тебе для здоровья. Быть довольной своим внешним видом и всегда испытывать бодрость и энергию - легко. Подпишись и мы расскажем как.
Реклама: @Ae_sered

Доктор Хайров | Здоровье без крайностей
@doctorkhayrov
12.6K
🥦 Сохраняю здоровье взрослым и детям
💊Перестанете сливать бюджет в аптеку.
🩻15 лет успешной врачебной практики
LINK

Похудение | Диета | Фитнес
@pohudey_tg
12.6K
Только ты и только от тебя зависит твоё здоровье и красота. Так что возьми себя в руки, а с остальным мы тебе поможем!
Реклама: @gregory_rekLama
Зарегистрирован в РКН - LINK

Нутрициолог Евгения Кузьменко |АИТ|ГИПОТИРЕОЗ|ЛИШНИЙ ВЕС
@prevent_jenny
12.6K
• Нутритерапевт Великобритания (CNM), США (IFM)
• Помогла более 50 000 участникам моих программ
📲 Индивидуальная работа: LINK
Регистрация в перечне РКН:
LINK
Radiology short cases
@shortradiology
12.6K

Йога | Мастер Классы | Советы
@sovet_yoga
12.6K
Всё что ты хотел знать о йоге от профессионалов
Зарегистрирован в РКН: LINK
По вопросам рекламы - @DianaNevl

Рукето
@ruketo_ru
12.6K
Официальный канал магазина ruketo.ru
LINK
#SJSJR

Kissel Kitchen
@drkissel
12.6K
Публичный канал ИИ-проекта доктор Киссель
FODMAP и рецепты
Зарегистрирован РКН LINK
#ZON3P

Mr. Pool
@themrpool
12.6K
NOW PMURT

Эдуард Депелян | Рутина хирурга
@eduardsurg
12.6K
Моя каждодневная практика.
Выкладываю сюда все, что происходит у меня на приеме каждый день.
Ссылка на инстаграм:
LINK

Фитнес | Похудение | Диета
@hudey_kayfuy
12.6K
Рабочие приемы и диеты для похудения и сохранения фигуры. Подписывайся, чтобы быть стройной всегда!
Реклама: @serrafima
Зарегистрирован в РКН: LINK

💧 GesundBrunnen - Liebe dein Leben
@gesundbrunnen
12.6K
Gesundheit ist das A und O! Hier findest du alles rund um das Thema Gesundheit und wie es anders gehen kann. Gib deinen Selbstheilungskräften und vor allem Mutter Natur eine Chance 🌱
Kontakt: @GesundBrunnen_bot

Доктор Тегай. Пластический хирург
@drtegay
12.6K
Пластический хирург Тегай Роман Артурович. Оперирую в Москве.
Запись на консультацию: +7(980)-150-07-77
#QTNGA

ПОЛЕЗНЫЕ ПРИВЫЧКИ♀️массаж, осанка, молодость, интуитивное питание, похудение.
@vvvozhegov
12.6K
Канал для женщин💃
Уроки естественного омоложения своими руками от телеведущей и многодетной мамы, Валентины 🌷
Время нельзя остановить, но с ним можно подружиться 🌺 #DGHEZ
Курсы
LINK
Клуб
LINK

Военно-медицинская подготовка|
@tacmed_z
12.5K
Просто читай.
Не дай Бог, конечно, но может пригодиться.
РКН 5660781618
Для связи @eshsga

𝑪𝒍𝒊𝒏𝒊𝒄𝒂𝒍 𝑫𝒆𝒓𝒎𝒂 𝑯𝒖𝒃
@medicales1
12.5K
❖ **🅳🆁. 🅺🅶** ❖
➤ 𝑻𝒉𝒆 𝒂𝒅𝒗𝒂𝒏𝒄𝒆𝒅 𝒅𝒆𝒓𝒎𝒂𝒕𝒐𝒍𝒐𝒈𝒚 𝒄𝒉𝒂𝒏𝒏𝒆𝒍
➤ 𝒇𝒐𝒓 𝒆𝒂𝒔𝒚, 𝒒𝒖𝒊𝒄𝒌, 𝒂𝒏𝒅 𝒑𝒓𝒐𝒇𝒆𝒔𝒔𝒊𝒐𝒏𝒂𝒍 𝒔𝒌𝒊𝒍𝒍𝒔 𝒅𝒆𝒗𝒆𝒍𝒐𝒑𝒎𝒆𝒏𝒕.

Vademecum
@vademecum_ru
12.5K
№ 4945809874
Деловой журнал об индустрии здравоохранения Vademecum
По поводу рекламы: @Elena1329
Новости нон-стоп в канале LINK

🍃 EinfachLynni - Einfach gesund!
@einfachlynni
12.5K
Inspirationen die Körper, Geist & Seele nähren:
✨Lebenskraft für Mensch & Tier
✨Naturmedizin & Kräuterwissen
✨Altes Heilwissen neu entdeckt
✨Naturkosmetik & chemiefreier Haushalt
✨Kreative Rezepte
Schön, dass du hier bist! 🌼
Blog: www.einfachlynni.de